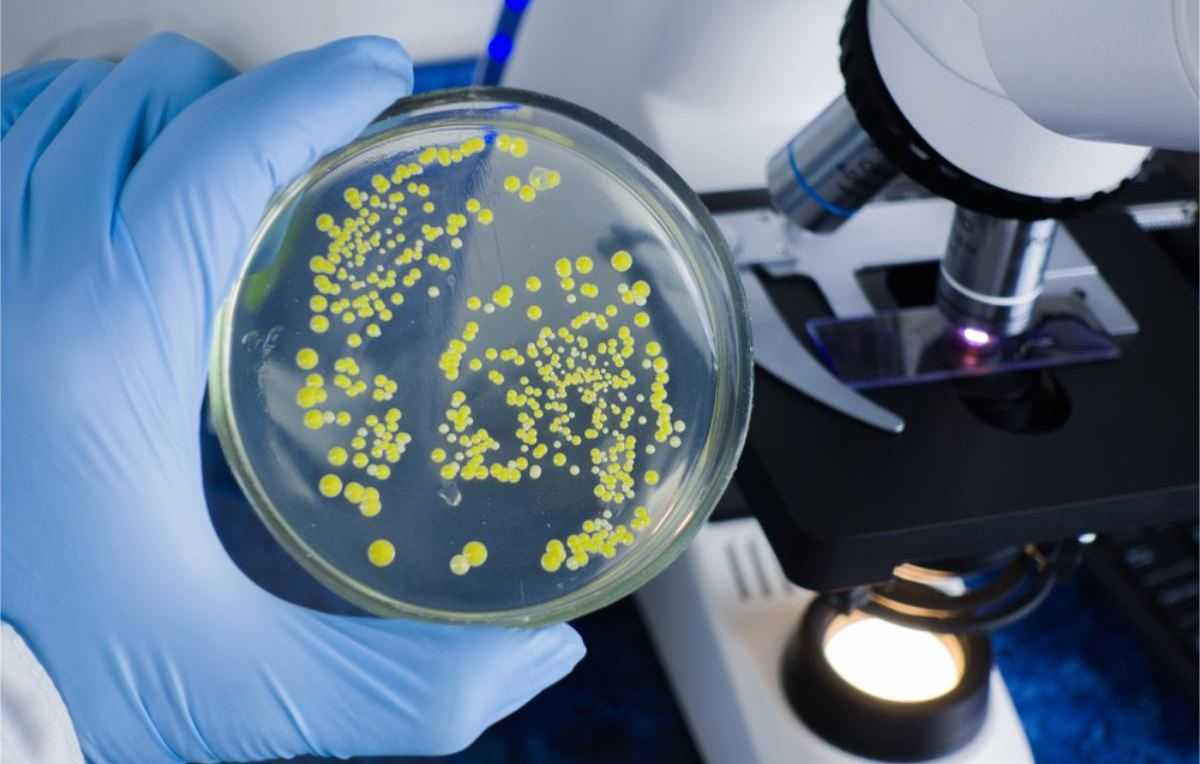
Bacteriën

Deze plek in de keuken zit vol bacteriën
Bacteriën zijn alomtegenwoordig, ook in elk huis zijn ze aanwezig. Er is echter een plekje waar ze welig tieren.
Een dat is in de keukengootsteen. "In het gemiddelde huis leven tot wel 8.000 verschillende soorten bacteriën. Ook in onze keukenwasbakken voelen de micro-organismen zich thuis", zegt Enya Arconada Nuin, een doctoraatsonderzoekster verbonden aan het Laboratorium voor Medische Microbiologie (UAntwerpen).
"Er komt van alles in de keukengootsteen terecht: etensrestjes, schoonmaakmiddelen, potgrond, huisdierenvacht... Daardoor is het echt een hotspot van bacteriën."
Arconada Nuin lanceert nu samen met haar (co)promotoren prof. Sandra Van Puyvelde en prof. Gert-Jan de Bruijn het burgerwetenschapsproject 'POEMBAKterie'. Zo wil men zicht krijgen op welke bacteriën er precies in de gootstenen van de Antwerpenaren voorkomen.
Aan de deelnemers wordt gevraagd om een staaltje genetisch materiaal uit hun keukengootsteen te nemen en een vragenlijst in te vullen. De swabs zullen in het labo onderzocht worden en de resultaten worden nadien meegedeeld aan de deelnemers. Meedoen kan via Poembakterie.be.
Muffe geurtjes in de gootsteen
"We verwachten zowel goede als slechte bacteriën aan te treffen. Onder 'slechte' bacteriën verstaan we bijvoorbeeld soorten die voor muffe geurtjes in de gootsteen zorgen, maar evengoed organismen die onze gezondheid kunnen schaden."
"Een extreem voorbeeld is de hardnekkige ziekenhuisbacterie Serratia marcescens, die goed gedijt in vochtige omgevingen zoals wasbakken. Toen die bacterie in 2019 in ons land uitbrak op de intensieve zorgen in een ziekenhuis, kwamen er drie jonge kinderen om het leven."
Al hoeven we niet alle bacteriën in de keukengootsteen te vrezen. "Sommige 'goede' bacteriën verdringen zelfs net de slechte soorten. Niet alleen in ons lichaam is dat geval, maar dus ook in de gootsteen."
























































